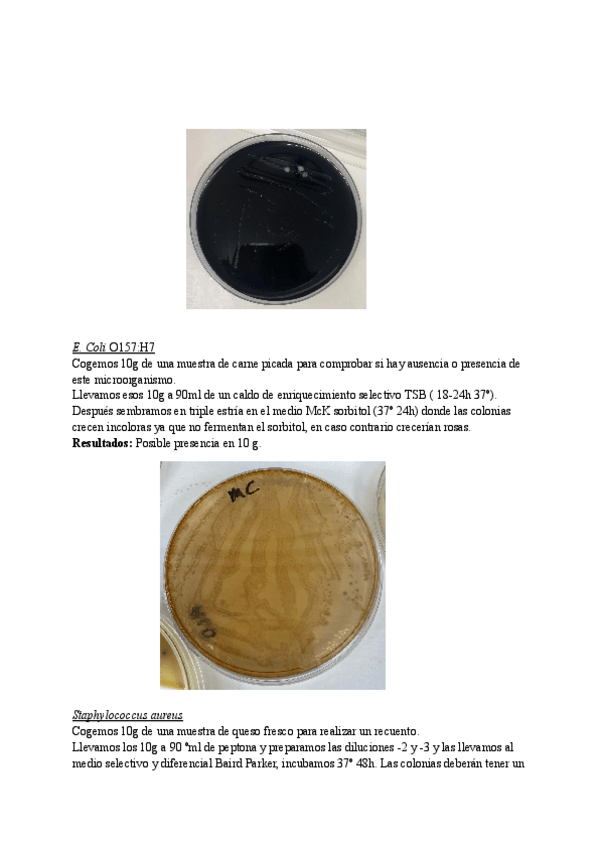

@lfg__
25 Publicaciones
367 Interacciones
1 Seguidores
3 Siguiendo
Lista de publicaciones de lfg__
He publicado nuevos apuntes de 3º Nutrición Humana: Informe-Nutricion-Humana-Lidia.pdf
He publicado nuevos apuntes de 3º Bioquímica de los Alimentos: 2-parte-BQA.pdf
He publicado nuevos apuntes de 2º Propiedades Físicas de Los Alimentos: Examenes-propiedades.docx
apuntes
-
BLOQUE 1 TOXI
He publicado nuevos apuntes de 3º Toxicología Alimentaria: BLOQUE 1 TOXI
He publicado nuevos practicas de 2º Higiene Alimentaria: Informe-practicas-higiene-modulo-II.pdf
He publicado nuevos apuntes de 2º Bromatología Descriptiva: Composicion-nutricional.pdf
He publicado nuevos practicas de 2º Bioquímica I: Seminario-secuencia-genica.pdf
He publicado nuevos apuntes de 1º Análisis Químico: Tipos-De-Calibraciones.pdf
He publicado nuevos apuntes de 2º Bioquímica I: Tema-9Vitaminas-y-coenzimas.pdf
He publicado nuevos apuntes de 1º Química II: Apuntes-quimica-1er-parcial.pdf
He publicado nuevos apuntes de 1º Estructura y función del cuerpo humano: Fisiologia-hasta-tema-6.pdf
He publicado nuevos apuntes de 1º Matemáticas: Todos los apuntes Matemáticas.pdf
He publicado nuevos practicas de 1º Biología: Biologia-vegetal-informe.pdf